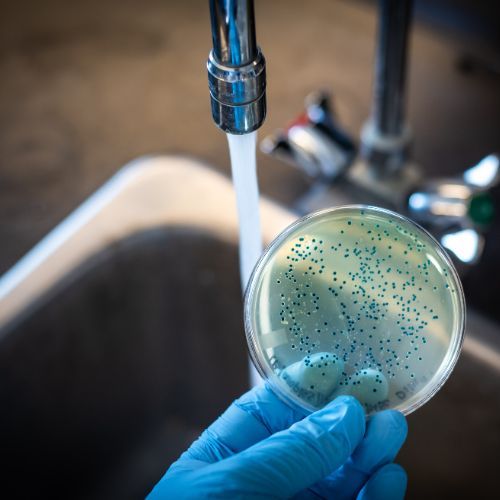

Alarm epidemiologiczny za zachodnią granicą. Czy zagrożenie dotrze do Polski?
Największe od lat ognisko EHEC w pobliżu polskiej granicy
W Meklemburgii-Pomorzu Przednim, zaledwie kilkadziesiąt kilometrów od granicy Polski, rozprzestrzenia się największe od dawna ognisko zakażeń bakterią Escherichia coli typu EHEC. Do dnia 19 września 2025 roku potwierdzono tam już 78 przypadków infekcji, z czego aż 15 dotknęło dzieci z groźnym zespołem hemolityczno-mocznicowym (HUS).
Zbliżający się sezon jesienny, a wraz z nim wzrost infekcji dróg oddechowych, budzi obawy o to, czy „koktajl patogenów” nie przedostanie się także do Polski. W samym tylko landzie stwierdzono 78 zakażeń, a w całych Niemczech łącznie 89. Spośród nich 21 infekcji przypisano jednoznacznie do bieżącego ogniska, a 15 przebiegało z komplikacjami w postaci HUS.

Rośnie również liczba infekcji dróg oddechowych w Niemczech
Tylko w pierwszym tygodniu września 3,8 mln Niemców zgłosiło objawy ostrej infekcji dróg oddechowych. Ubiegłej zimy sytuacja była jeszcze poważniejsza, kiedy to tzw. „tridemia”, czyli jednoczesne występowanie grypy, COVID-19 i wirusa RSV, dotknęła około 9 mln osób.
W tej sytuacji Polska Inspekcja Sanitarna nie pozostaje bierna. Zapowiedziano przygotowanie szczegółowych instrukcji dla placówek działających przy granicy oraz aktywne monitorowanie ruchu turystycznego na przejściach drogowych w celu wczesnego wykrywania i przeciwdziałania możliwemu rozprzestrzenianiu się chorób.
Północne landy Niemiec wzbudzają niepokój epidemiologów
Najwięcej przypadków zakażeń EHEC odnotowano w powiatach Vorpommern-Greifswald oraz Vorpommern-Rügen, popularnych wśród Polaków na weekendowe wypady nad Bałtyk. Od połowy sierpnia obserwuje się gwałtowny wzrost liczby zachorowań – z kilkunastu do 78 potwierdzonych przypadków, z czego co piąty wymagał hospitalizacji.
Instytut Roberta Kocha podaje, że 57 spośród zakażeń to wstępne diagnozy oczekujące na potwierdzenie, jednak wszystkie łączą identyczny serotyp bakterii (O45:H2) i pobyt na północy Niemiec na kilka dni przed wystąpieniem objawów. Epidemiolodzy prowadzą obecnie śledztwo dotyczące potencjalnego źródła zakażenia, w tym łańcucha dostaw żywności i lokalnych ujęć wody, choć jak na razie brak przesłanek wskazujących na ogólnokrajową falę infekcji.
Sezonowa „tridemia” to dodatkowe wyzwanie dla służby zdrowia
Enterohemoragiczna Escherichia coli (EHEC) produkuje toksyny prowadzące do uszkodzenia naczyń włosowatych w jelitach oraz nerkach. Choroba rozpoczyna się zwykle biegunką, często z krwią, gorączką i bólami brzucha. U części dzieci skutkuje ona poważnymi powikłaniami, w tym niewydolnością nerek.
Obecnie Niemcy rozpoczynają sezon infekcji drogą oddechową, w tym grypy, COVID-19 oraz RSV, które razem z epidemią EHEC zwiększają presję na system ochrony zdrowia. Warto znać najważniejsze dane:
- 78 zgłoszonych przypadków EHEC na terenie Meklemburgii, z czego 15 zakończyło się rozwojem HUS – to aż 19% wszystkich infekcji;
- W grudniu 2024 roku „tridemia” objęła około 9 mln mieszkańców Niemiec, co stanowiło około jednego na dziewięciu obywateli;
- We wrześniu 2025 notowano już 3,8 mln nowych infekcji dróg oddechowych, ze szczególnym wzrostem wśród dorosłych.
Jak zadbać o swoje zdrowie podczas podróży?
Chociaż Główny Inspektorat Sanitarny nie wprowadził jeszcze stanu zagrożenia epidemiologicznego, szpitale zakaźne w Szczecinie, Gorzowie Wielkopolskim i Zielonej Górze przygotowują dodatkowe łóżka dla pacjentów z ostrą biegunką krwotoczną.
Przed planowanym wyjazdem do północnych Niemiec lub przyjmowaniem niemieckich turystów, warto przestrzegać kilku kluczowych zasad, które mogą znacząco zmniejszyć ryzyko zachorowania:
- Przed podróżą – sprawdź bieżące komunikaty Instytutu Roberta Kocha oraz Głównego Inspektoratu Sanitarnego; rozważ też profilaktyczne szczepienia przeciw grypie oraz dawki przypominające przeciw COVID-19;
- Podczas pobytu – unikaj surowych warzyw, niepasteryzowanych soków i surowego mięsa; dbaj o higienę rąk, myjąc je dokładnie mydłem po kontakcie z powierzchniami publicznymi;
- Po powrocie – obserwuj swój stan zdrowia przez 10 dni. Jeśli pojawi się krwista biegunka, wysoka gorączka bądź objawy odwodnienia, niezwłocznie skontaktuj się z lekarzem, zwłaszcza jeśli chorują dzieci, kobiety w ciąży lub osoby starsze.
Ważne jest, aby nie stosować domowych metod leczenia bez wcześniejszej konsultacji medycznej. Antybiotyki nie powinny być podawane profilaktycznie, szczególnie dzieciom. W przypadku ciężkiego odwodnienia decyzję o terapii dożylnej podejmuje personel medyczny.
Komentarze